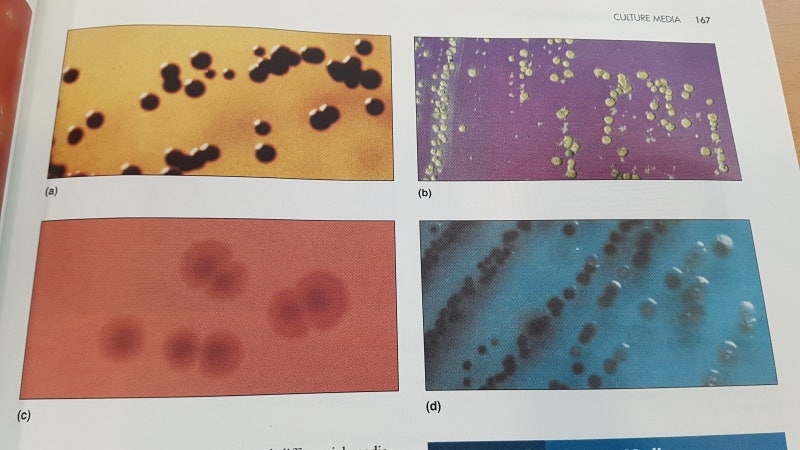

세균을 구제하는 데 항생제만큼 좋은 약은 없습니다. 페니실린을 필두로 지금까지 개발된 다양한 항생제 덕분에 사망률이 획기적으로 감소했습니다. 세균성 질염의 치료에도 항생제는 꼭 있어야 하는 약입니다. 하지만 그 이면에는 항생제를 사용하지 않으려고 몸부림치는, 혹은 더 이상 항생제가 소용없다고 호소하는 많은 분들이 있습니다. 오늘은 세균성 질염을 치료할 때 항생제를 올바르게 사용하는 방법과 유산균 치료에 대해 알아보겠습니다.

질 내부에는 매우 다양하고 많은 세균들이 서식하고 있는데 이들을 합쳐서 질내세균총이라고 하는데 질내세균총의 절반 이상을 단 한 종류의 질유산균이 차지하고 있습니다. 어떤 종류의 질유산균이 살고 있는지는 개인차가 있기 때문에 여성분들은 서로 다른 종류의 질유산균을 보유하고 있는 것입니다.

세균성 질염으로 인한 증상이 나타나고 STD 검사에서 특정 세균이 검출되려면 적어도 질유산균보다 병원균이 많아져야 합니다. 평소 질유산균 활성이 정상이었던 분들은 병원균이 굉장히 많이 증가해야 질유산균을 넘어설 수 있습니다. 이때 나타나는 세균성 질염은 증상이 상당히 심합니다. 분비물도 많이 나오고 간지럽거나 따끔거리는 증상도 참을 수 없을 정도로 심해서 병원을 찾습니다. 이 경우 절대적인 세균량이 많기 때문에 항생제 치료를 계획하는 것이 좋습니다. 항생제가 유익균인 질산균도 없애지만 유해균인 병원성 세균을 없애는 장점이 더 크므로 일단 항생제를 사용하여 세균성 질염을 치료하고 이후 유산균이 회복되는지 지켜보거나 적극적인 유산균 치료를 계획합니다.

그러나 만성 질염의 경우 상황은 전혀 다릅니다. 위의 경우와 다른 종류의 세균성 질염이라고 봐도 상관 없습니다. 반복되는 세균성 질염을 치료하기 위해서 항생제를 반복 사용하면 질 유산균이 감소하고 병원성 세균의 증가 폭이 적어도 질 염증장이 나타나는 일이 있습니다. 같은 세균에 의한 세균성 질염에서도 세균의 절대량이 적기 때문에 증상은 그리 나쁘지 않습니다. 어떤 경우에도 치료하지 않아도 그럭저럭 지낼수록 자연스럽게 회복하기도 합니다. 만약 이런 만성 질염의 때 소량의 세균을 없애기 위해서 항생제를 사용하면, 세균을 없애는 장점보다 가뜩이나 손상된 질 유산균을 없애는 단점이 더 큰 상황입니다.이 경우 항생 물질의 사용은 철저히 금지합니다. 대신 지방질 유산균의 활성을 높일 수 있는 유산균 치료를 계획합니다. 유산균 치료 중에 불쾌한 세균성 질염의 증상이 발생한 경우 질산균의 활성에 큰 영향을 미치지 않은 천연 항균 물질을 이용한 약을 활용합니다. 세균의 증가 폭이 크지 않고 천연 추출물만으로도 충분한 관리가 가능합니다.

유산균 치료의 핵심은 자궁순환 개선입니다. 유산균을 복용하거나 질정 형태로 주입하는 것은 개인마다 다른 질내 환경에 외래 균을 주입한 것이므로 잘 자라기는 쉽지 않고 장기간 유지되지도 않습니다. 가장 좋은 것은 본인이 질 내부에 가지고 있던 유산균이 다시 활성을 보이면서 서서히 활동성을 높여가는 것입니다. 세균성 질염의 원인이 병원균의 증가보다 유산균의 감소에 있는 만큼 유산균 치료를 통해 질산균의 활성을 높이면 재발하지 않고 안정된 상태를 유지할 수 있습니다.

세균성 질염을 치료하기 위해 시행한 유산균 치료 결과 질 유산균 활성 회복 여부는 질 내 산성도 검사를 통해 확인할 수 있습니다. 질산균의 활성이 높아지면 질내 환경이 점차 약산성 환경으로 변화하지만 주기적인 질내 산성도 검사를 실시하면 점차 약산성 환경으로 회복되는 모습을 볼 수 있습니다. 세균성 질염을 치료하려면 항생제를 사용할 필요가 있는 경우와 사용해서는 안 되는 경우를 정확히 구별할 수 있어야 합니다. 세균성 질염을 치료하기 위한 유산균 치료를 계획하고 주기적인 확인을 통해 질 유산균의 활성이 회복되는지 살펴보면 더 이상 세균성 질염이 반복될 가능성은 없어질 것입니다.